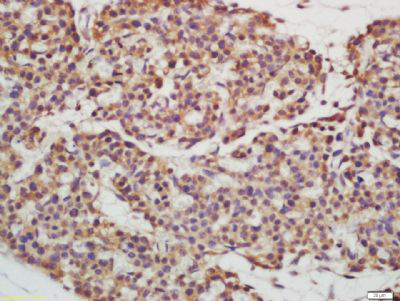
产品细节图片1

相关产品推荐更多 >
万千商家帮你免费找货
0 人在求购买到急需产品
- 详细信息
- 文献和实验
- 技术资料
- 供应商:
江西江蓝纯生物试剂有限公司
- 库存:
113
- 克隆性:
单克隆
- 保质期:
1年
- 抗体英文名:
EPS15R
- 抗体名:
表皮生长因子受体底物15抗体
- 适应物种:
人/动物/植物
- 应用范围:
WB,ELISA等
- 浓度:
1mg/ml
- 保存条件:
-20 °
- 规格:
100ul/200ul
| 规格: | 100ul | 产品价格: | ¥1580.0 |
|---|---|---|---|
| 规格: | 200ul | 产品价格: | ¥2480.0 |
英文名称 : EPS15R
中文名称 : 表皮生长因子受体底物15抗体
别 名 : epidermal growth factor receptor pathway substrate 15- ike 1; Epidermal growth factor receptor substrate 15 like 1; epidermal growth factor receptor substrate EPS15R; Eps15 related protein; eps15R;EP15R_HUMAN.
研究领域 : 细胞生物 生长因子和激素 激酶和磷酸酶 表观遗传学
抗体来源 : Rabbit
克隆类型 : Polyclonal
交叉反应 : Human, Mouse, Rat, Dog, Pig, Cow, Horse, Rabbit, Sheep,
产品应用 : WB=1:500-2000 ELISA=1:500-1000 IHC-P=1:400-800 IHC-F=1:400-800 ICC=1:100-500 IF=1:100-500 (石蜡切片需做抗原修复)
not yet tested in other applications.
optimal dilutions/concentrations should be determined by the end user.
分 子 量 : 94kDa
细胞定位 : 细胞核 细胞膜
性 状 : Lyophilized or Liquid
浓 度 : 1mg/ml
免 疫 原 : KLH conjugated synthetic peptide derived from human EPS15R:275-380/864
亚 型 : IgG
纯化方法 : affinity purified by Protein A
储 存 液 : 0.01M TBS(pH7.4) with 1% BSA, 0.03% Proclin300 and 50% Glycerol.
保存条件 : Store at -20 °C for one year. Avoid repeated freeze/thaw cycles. The lyophilized antibody is stable at room temperature for at least one month and for greater than a year when kept at -20°C. When reconstituted in sterile pH 7.4 0.01M PBS or diluent of antibody the antibody is stable for at least two weeks at 2-4 °C.
PubMed : PubMed
产品介绍 : Elucidation of the mechanism by which receptor tyrosine kinases (RTKs) modulate cellular physiology in response to stimuli is critical to the understanding of growth regulation, as miscues in RTK signaling can result in cellular transformation events that may ultimately lead to cancer. Eps15 (EGF-receptor pathway substrate 15) is an EGF receptor substrate that become become tyrosine phosphorylated subsequent to EGF stimulation. Over expression of Eps15 in NIH/3T3 cells causes cellular transformation, implying involvement of Eps15 in the regulation of cell proliferation. Eps15R (Eps15-related), also known as Eps15L1 (epidermal growth factor receptor substrate 15-like 1), is an 864 amino acid protein that contains one EF-hand domain and three EH domains. Localized to a variety of places within the cell, including the nucleus, cytoplasm and membrane-coated pits, Eps15R is thought to function as a component of clathrin-coated pits. Like Eps15, Eps15R may play an important role in receptor-mediated endocytosis.
Function:
EPS15 and EPS15R are substrates of the epidermal growth factor (EGF) receptor kinase, which are characterized by their ability to bind to the clathrin adaptor protein complex adaptor protein 2, and the presence of a protein:protein interaction domain, the EH domain. Evidence suggests that EPS15 and EPS15R are involved in endocytosis. The major difference between these two related proteins is that EPS15R is also found in the nucleus, whereas EPS15 is excluded from this compartment at steady state.
Subunit:
Interacts with EPS15, AGFG1/HRB and AGFG2/HRBL. Associates with the clathrin-associated adapter protein complex 2 (AP-2) (By similarity). Interacts with FCHO1. Interacts with FCHO2. Interacts (via EH domains) with DAB2.
Subcellular Location:
Cell Membrane and Nuclear.
Post-translational modifications:
Phosphorylated on tyrosine residues by EGFR (By similarity).
Similarity:
Contains 1 EF-hand domain.
Contains 3 EH domains.
SWISS:
Q9UBC2
Gene ID:
58513
Important Note:
This product as supplied is intended for research use only, not for use in human, therapeutic or diagnostic applications.
产品图片
风险提示:丁香通仅作为第三方平台,为商家信息发布提供平台空间。用户咨询产品时请注意保护个人信息及财产安全,合理判断,谨慎选购商品,商家和用户对交易行为负责。对于医疗器械类产品,请先查证核实企业经营资质和医疗器械产品注册证情况。
 文献和实验
文献和实验厦门大学药物科学学院的研究团队已经发现表皮生长因子受体(EGFR)在三阴乳腺癌肿瘤位置高表达,并设计了靶向EGFR 的第三代 CAR 结构。随后用 EGFR CAR 慢病毒(EGFR CAR-T)感染原代T淋巴细胞生产 CAR-T,分别在体外和体内评估了 CAR-T 对 TNBC 的疗效。通过RNA测序分析揭示了 EGFR CAR-T 细胞中激活的信号通路情况。 结果发现:第三代 EGFR CAR-T 细胞在体外对 TNBC 肿瘤细胞有很强的特异性抑制作用,而对正常的乳腺上皮细胞或雌激素受体
(EGF) 再与 HRP 标记抗体结合,形成抗体 - 抗原 - 酶标抗体复合物,经过彻底洗涤后加底物 TMB 显色。 TMB 在 HRP 酶的催化下转化成蓝色,并在酸的作用下转化成最终的黄色。颜色的深浅和样品中的 表皮生长因子 (EGF) 呈正相关。用酶标仪在 450nm 波长下测定吸光度( OD 值),通过标准曲线计算样品中大鼠 表皮生长因子 (EGF) 浓度。 试剂盒组成 : 试剂盒组成
) 再与HRP 标记抗体结合,形成抗体 - 抗原 - 酶标抗体复合物 ,经过彻底洗涤后 加 底物TMB 显色。 TMB 在 HRP 酶的催化下转化成蓝色,并在酸的作用下转化成最终的黄色。颜色的深浅和样品中的 表皮生长因子 ( E GF) 呈正相关。用酶标仪在 450 nm波长下测定吸光度( OD 值), 通过标准曲线 计算样品 中猪 表皮生长因子 ( E GF) 浓度。 试剂盒组成 : 试剂盒组成
 技术资料
技术资料暂无技术资料 索取技术资料










